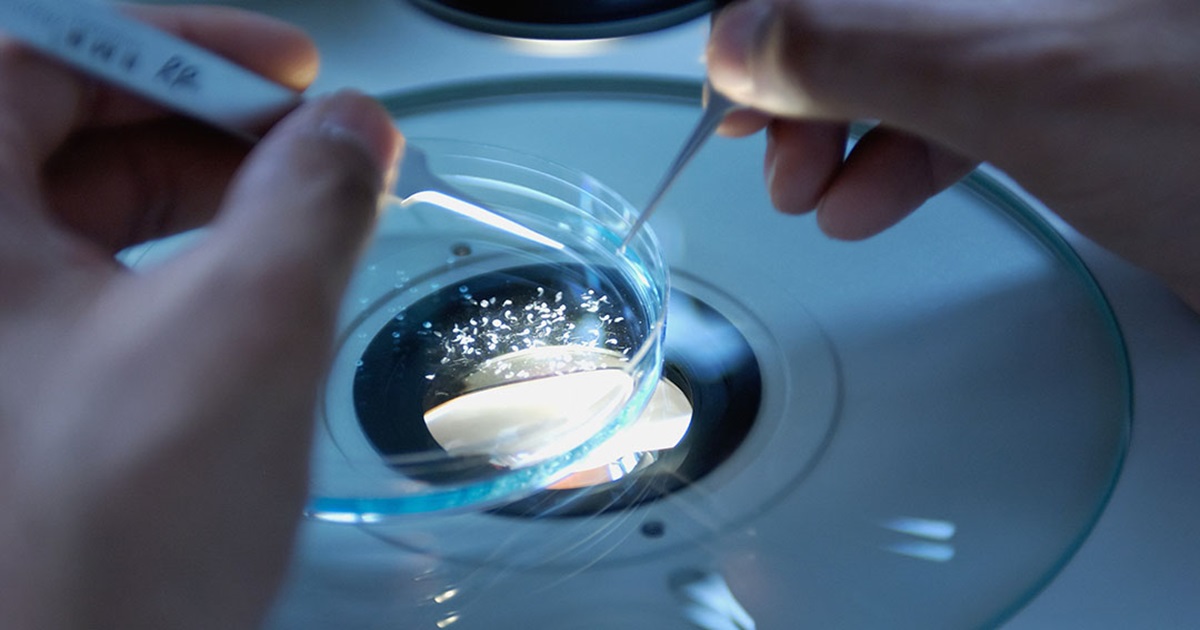
bacterium killed tumors more effectively than cancer drugs in mice body new experiment in japan

মাধ্যম নিউজ ডেস্ক: ক্যানসার কোষ ধ্বংস করবে ব্যাক্টেরিয়া! কর্কট রোগের চিকিৎসায় বহু পুরনো ব্যাক্টেরিয়া-থেরাপিকে ফিরিয়ে আনছেন বিজ্ঞানীরা। ক্যানসার চিকিৎসা (Cancer Drugs) বলতে এখনও মূলত অস্ত্রোপচার, কেমোথেরাপি ও ইমিউনোথেরাপিকেই বোঝানো হয়। তবে সাম্প্রতিক বছরগুলোতে বিজ্ঞানীরা মানবদেহের বাইরের জগতের দিকেও নজর দিচ্ছেন—বিশেষ করে প্রাকৃতিক অণুজীব বা ব্যাকটেরিয়ার (Bacterium Killed Tumors) দিকে। সেই গবেষণার ধারাবাহিকতায় জাপানের এক নতুন গবেষণা ক্যানসার চিকিৎসা নিয়ে নতুন সম্ভাবনার দরজা খুলে দিয়েছে।
সংক্রামক ব্যাকটেরিয়া দিয়ে ক্যানসার বধ
ক্যানসার বধের অস্ত্র তৈরি হচ্ছে সংক্রামক ব্যাকটেরিয়াদের দিয়েই। শরীরে জীবাণু ঢুকিয়ে মারণরোগ সারানোর পন্থা আবিষ্কারের দাবি করেছেন বিজ্ঞানীরা। জাপান অ্যাডভান্সড ইনস্টিটিউট অব সায়েন্স অ্যান্ড টেকনোলজি (JAIST)-এর অধ্যাপক এইজিরো মিয়াকোর নেতৃত্বে পরিচালিত এই গবেষণাটি প্রকাশিত হয়েছে আন্তর্জাতিক বিজ্ঞান সাহিত্য গাট মাইক্রোবস-এ। গবেষণায় ব্যাঙ ও সরীসৃপের অন্ত্র থেকে সংগ্রহ করা এক প্রাকৃতিক ব্যাকটেরিয়া ইঁদুরের শরীরে টিউমার সম্পূর্ণভাবে ধ্বংস করতে সক্ষম হয়েছে। গবেষকরা জাপানি ট্রি ফ্রগ, ফায়ার-বেলি নিউট এবং ঘাসে বসবাসকারী টিকটিকির অন্ত্র থেকে মোট ৪৫ ধরনের ব্যাকটেরিয়া আলাদা করে পরীক্ষা করেন। এর মধ্যে ৯টি ব্যাকটেরিয়া পরীক্ষাগারে ক্যানসার কোষের বিরুদ্ধে কার্যকর প্রমাণিত হয়।
এক ডোজেই টিউমার সম্পূর্ণ নির্মূল
সবচেয়ে উল্লেখযোগ্য ফল দেখায় ইউনগেলা আমেরিকানা (Ewingella americana) নামের একটি ব্যাকটেরিয়া। যা জাপানি ট্রি ফ্রগের অন্ত্রে স্বাভাবিকভাবেই পাওয়া যায়। এই ব্যাকটেরিয়াটি জেনেটিকভাবে পরিবর্তিত নয়, সম্পূর্ণ প্রাকৃতিক। কোলোরেক্টাল ক্যানসারে আক্রান্ত ইঁদুরের ওপর পরীক্ষায় দেখা যায়, মাত্র একবার শিরায় এই ব্যাকটেরিয়া প্রয়োগ করার পর সব ইঁদুরের টিউমার সম্পূর্ণভাবে অদৃশ্য হয়ে যায়। গবেষকদের মতে, এই ফলাফল প্রচলিত ক্যানসার ওষুধ যেমন ডক্সোরুবিসিন বা অ্যান্টি-পিডি-এল-১ (PD-L1) ইমিউনোথেরাপির চেয়েও বেশি কার্যকর ছিল।
দুইভাবে ক্যানসার আক্রমণ
গবেষণায় জানা গিয়েছে, এই ব্যাকটেরিয়া (Bacterium Killed Tumors) দুইটি ভিন্ন পথে ক্যানসার কোষ ধ্বংস করে। প্রথমত, টিউমারের ভেতরে অক্সিজেনের মাত্রা কম থাকায় সেখানে ব্যাকটেরিয়াটি দ্রুত বৃদ্ধি পায়। ২৪ ঘণ্টার মধ্যে টিউমারের ভেতরে ব্যাকটেরিয়ার সংখ্যা প্রায় ৩ হাজার গুণ বেড়ে গিয়ে সরাসরি ক্যানসার কোষ ধ্বংস করে। দ্বিতীয়ত, ব্যাকটেরিয়াটি দেহের রোগপ্রতিরোধ ব্যবস্থাকে সক্রিয় করে তোলে। টিউমার এলাকায় টি-সেল, বি-সেল ও নিউট্রোফিলের মতো ইমিউন কোষ জমা হয়, যা TNF-α ও IFN-γ নামের গুরুত্বপূর্ণ সংকেত নিঃসরণ করে ক্যানসার কোষের মৃত্যু ঘটায়।
সুস্থ অঙ্গ-প্রত্যঙ্গে ক্ষতি হয়নি
ব্যাকটেরিয়া (Bacterium Killed Tumors) ব্যবহার করে ক্যানসার চিকিৎসার ক্ষেত্রে সবচেয়ে বড় উদ্বেগ নিরাপত্তা। গবেষণায় দেখা গিয়েছে, এই ব্যাকটেরিয়া ২৪ ঘণ্টার মধ্যেই রক্ত থেকে সরে যায় এবং যকৃত, ফুসফুস, কিডনি বা হৃদ্পিণ্ডের মতো সুস্থ অঙ্গে স্থায়ীভাবে জমা হয় না। ইঁদুরের শরীরে যে সামান্য প্রদাহ দেখা গিয়েছে, তা তিন দিনের মধ্যেই সেরে যায়। ৬০ দিন পর্যবেক্ষণের পরও কোনো দীর্ঘমেয়াদি বিষক্রিয়া পাওয়া যায়নি।
ভবিষ্যতের চিকিৎসায় সম্ভাবনা
গবেষকরা স্পষ্ট জানিয়েছেন, এটি এখনও মানবদেহে প্রয়োগযোগ্য চিকিৎসা নয়। তবে এই গবেষণা প্রমাণ করে যে প্রকৃতিতে থাকা অজানা অণুজীব ভবিষ্যতের ক্যানসার চিকিৎসায় গুরুত্বপূর্ণ ভূমিকা রাখতে পারে। আগামী দিনে স্তন ক্যানসার ও অগ্ন্যাশয়ের ক্যানসারসহ অন্যান্য রোগে এই পদ্ধতি পরীক্ষা করা হবে। সফল হলে, ভবিষ্যতে ব্যাকটেরিয়াভিত্তিক থেরাপি কেমোথেরাপির ওপর নির্ভরতা কমাতে পারে।
Leave a Reply